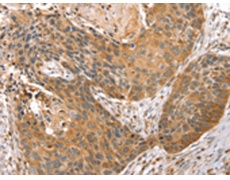
一抗

|
Background: |
This gene belongs to the syntaxin family and encodes a soluble N-ethylmaleimide sensitive factor attachment protein receptor (SNARE). The encoded protein is involved in docking and fusion events at the Golgi apparatus. Alternative splicing results in multiple transcript variants. |
|
Applications: |
ELISA, WB, IHC |
|
Name of antibody: |
STX10 |
|
Immunogen: |
Fusion protein of human STX10 |
|
Full name: |
syntaxin 10 |
|
Synonyms: |
SYN10; hsyn10 |
|
SwissProt: |
O60499 |
|
ELISA Recommended dilution: |
2000-10000 |
|
IHC positive control: |
Human esophagus cancer and human breast cancer |
|
IHC Recommend dilution: |
25-100 |
|
WB Predicted band size: |
28 kDa |
|
WB Positive control: |
Hela, lovo and A431 cells |
|
WB Recommended dilution: |
1000-5000 |


 購物車
購物車 幫助
幫助
 021-54845833/15800441009
021-54845833/15800441009